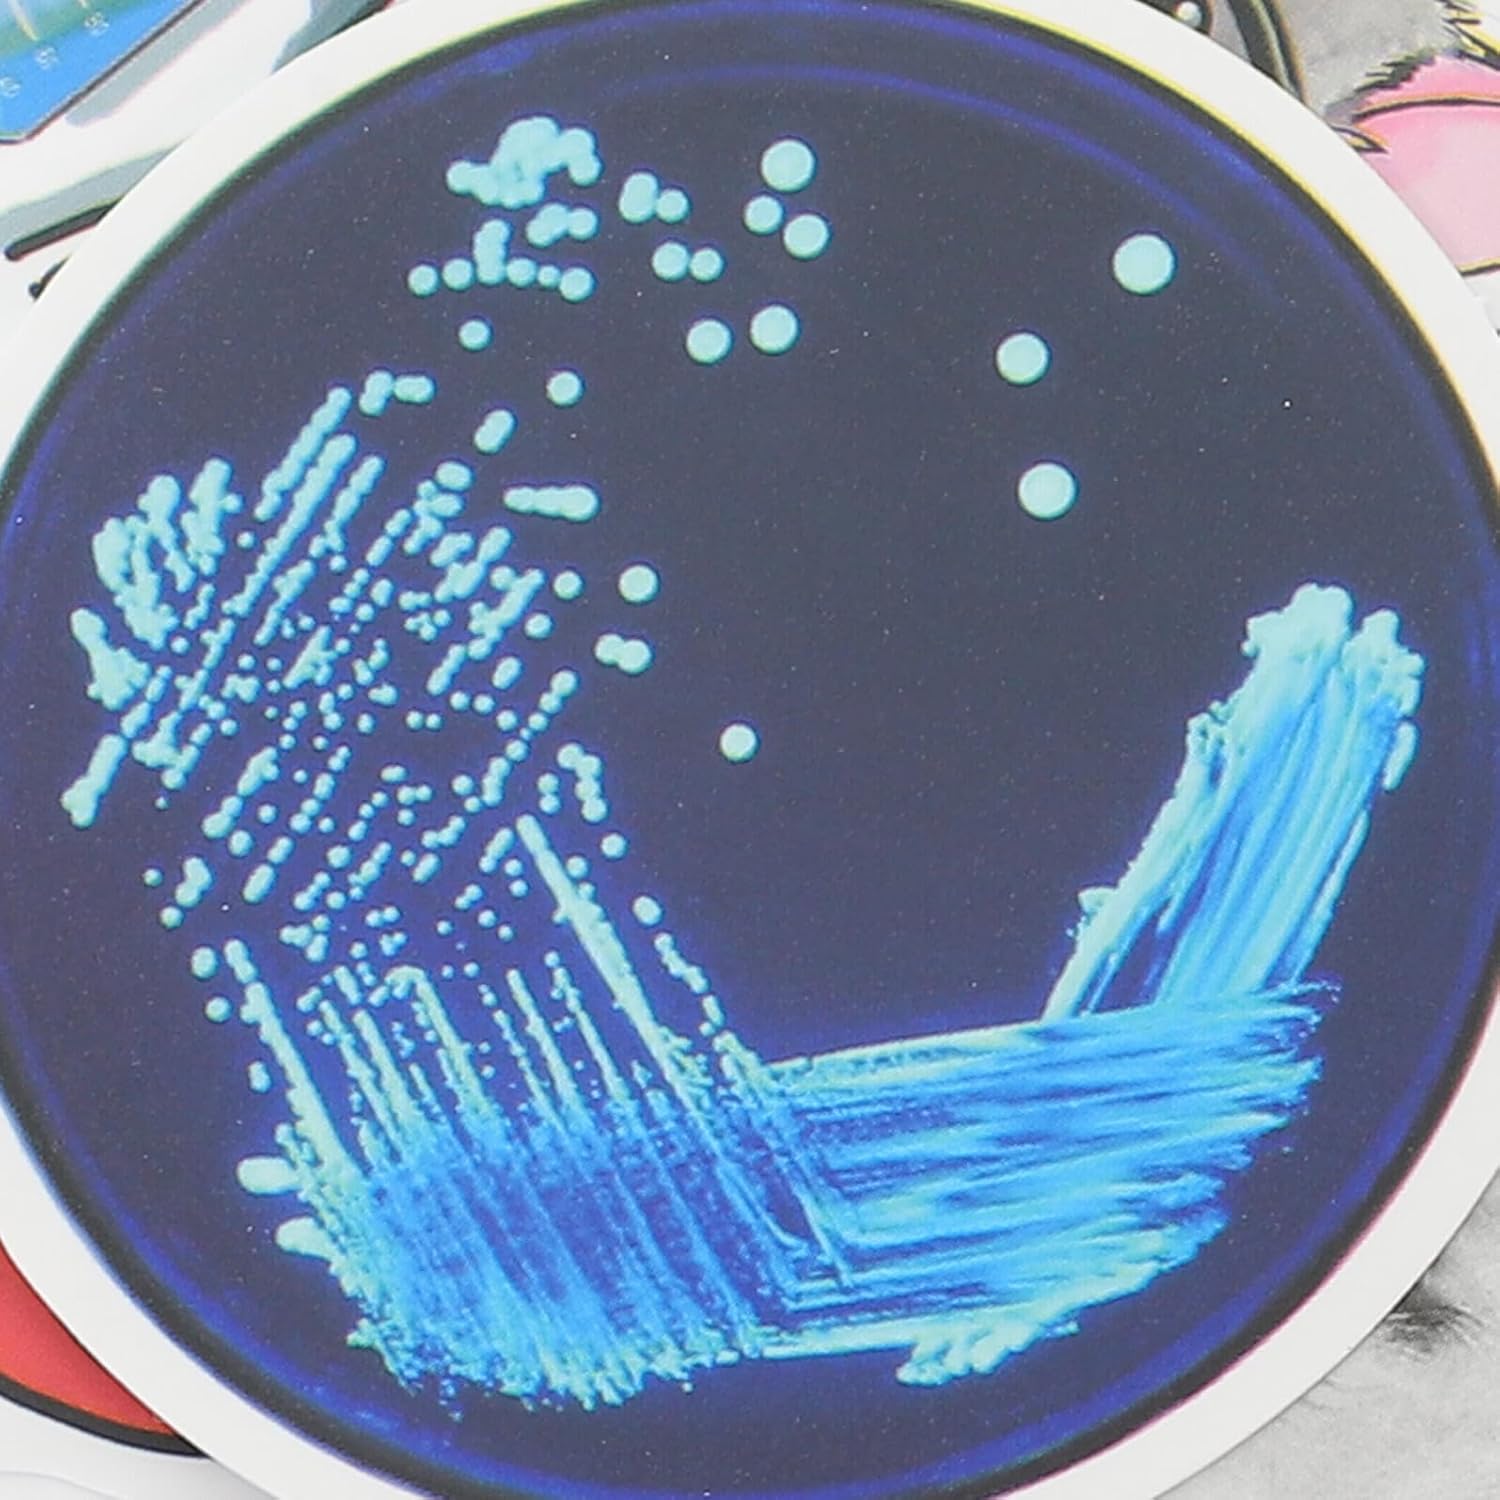

Brand:
Adesivo di scienze naturali: adatto per laptop, computer, valigie, diari e ovunque tu voglia, adesivi scientifici fai da te Adesivi scientifici: l'adesivo scientifico originale e decorativo è realizzato con un buon materiale per un uso duraturo e duraturo, diario di adesivi scientifici Adesivi di matematica e scienza: con design autoadesivo, facili da staccare e incollare, senza sbiadire, l'adesivo ultra forte fornisce un fissaggio ottimale su tutti i tipi di superfici, adesivi per scrapbooking Adesivi per valigie scientifiche: invia l'adesivo scientifico decorativo e originale ai tuoi amici come regalo, rendendoli felici, adesivo di biologia e chimica Libro di adesivi scientifici: il design unico è molto attraente, ti porta buon umore e una sensazione diversa, adesivi di fisica
EAN:
Categorie
Collezioni di adesivi
